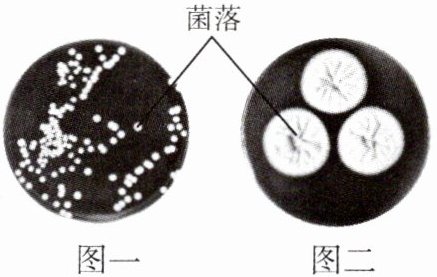

第68页
- 第1页
- 第2页
- 第3页
- 第4页
- 第5页
- 第6页
- 第7页
- 第8页
- 第9页
- 第10页
- 第11页
- 第12页
- 第13页
- 第14页
- 第15页
- 第16页
- 第17页
- 第18页
- 第19页
- 第20页
- 第21页
- 第22页
- 第23页
- 第24页
- 第25页
- 第26页
- 第27页
- 第28页
- 第29页
- 第30页
- 第31页
- 第32页
- 第33页
- 第34页
- 第35页
- 第36页
- 第37页
- 第38页
- 第39页
- 第40页
- 第41页
- 第42页
- 第43页
- 第44页
- 第45页
- 第46页
- 第47页
- 第48页
- 第49页
- 第50页
- 第51页
- 第52页
- 第53页
- 第54页
- 第55页
- 第56页
- 第57页
- 第58页
- 第59页
- 第60页
- 第61页
- 第62页
- 第63页
- 第64页
- 第65页
- 第66页
- 第67页
- 第68页
- 第69页
- 第70页
- 第71页
- 第72页
- 第73页
- 第74页
- 第75页
- 第76页
- 第77页
- 第78页
- 第79页
- 第80页
- 第81页
- 第82页
- 第83页
- 第84页
- 第85页
- 第86页
- 第87页
- 第88页
- 第89页
- 第90页
- 第91页
- 第92页
- 第93页
- 第94页
- 第95页
- 第96页
- 第97页
- 第98页
- 第99页
- 第100页
- 第101页
- 第102页
- 第103页
- 第104页
- 第105页
- 第106页
- 第107页
- 第108页
- 第109页
- 第110页
- 第111页
- 第112页
3. 下列是培养细菌和真菌的一般方法,排列顺序正确的是( )
①恒温培养 ②冷却 ③接种 ④高温灭菌 ⑤配制培养基
A.①④⑤③②
B.⑤④②③①
C.⑤②③④①
D.①⑤③④②
①恒温培养 ②冷却 ③接种 ④高温灭菌 ⑤配制培养基
A.①④⑤③②
B.⑤④②③①
C.⑤②③④①
D.①⑤③④②
答案:
B
4. 细菌和真菌的生活需要一定的条件。下列属于它们生活必需条件的是( )
①光照 ②有机物 ③空气 ④水 ⑤适宜的温度
A.①②③
B.②④⑤
C.③④⑤
D.①②③④
①光照 ②有机物 ③空气 ④水 ⑤适宜的温度
A.①②③
B.②④⑤
C.③④⑤
D.①②③④
答案:
B
5. 观察如图所示的菌落,下列有关描述错误的是( )

A.图一为细菌菌落,图二为真菌菌落
B.细菌形成的菌落常呈绒毛状、絮状或蜘蛛网状
C.菌落是由一个或多个细菌或真菌繁殖后形成的肉眼可见的子细胞群体
D.从菌落的形态、大小可以大致区分图一为细菌

A.图一为细菌菌落,图二为真菌菌落
B.细菌形成的菌落常呈绒毛状、絮状或蜘蛛网状
C.菌落是由一个或多个细菌或真菌繁殖后形成的肉眼可见的子细胞群体
D.从菌落的形态、大小可以大致区分图一为细菌
答案:
B 解析:真菌中的霉菌形成的菌落常呈绒毛状、絮状或蜘蛛网状。
6. 在“检测不同环境中的细菌和真菌”的探究实验中,下列有关说法错误的是( )
A.配制培养基时,牛肉汁的作用是为细菌和真菌的生存提供营养物质
B.配制好的培养基,在接种前必须进行高温灭菌处理
C.实验结束后,应将培养物等进行高温灭菌处理
D.接种后的培养基应经高温灭菌处理后再进行恒温培养
A.配制培养基时,牛肉汁的作用是为细菌和真菌的生存提供营养物质
B.配制好的培养基,在接种前必须进行高温灭菌处理
C.实验结束后,应将培养物等进行高温灭菌处理
D.接种后的培养基应经高温灭菌处理后再进行恒温培养
答案:
D
7. 手机在给人们带来沟通便捷的同时,也使越来越多的人患上“手机依赖症”。由于人的手经常接触手机,手机表面温暖、潮湿,非常适合细菌的生长。某文章称,手机屏幕比马桶按钮单位面积上的细菌多。某科研单位进行了如下研究,请分析回答下列问题。

|培养基编号|培养基组成|
|甲|牛肉汁、蔗糖、水等|
|乙|牛肉汁、琼脂、水等|

(1)如图,在固定面积用无菌棉签取样,制成细菌悬液,然后取该悬液在培养基上涂抹,这个步骤即为接种,该步骤前需要对培养基进行____。
(2)该实验需选用培养基____(填“甲”或“乙”),原因是____可以使培养基凝固,以便观察实验结果。
(3)培养基上生长的菌落有多种形态,如果菌落较大且呈绒毛状,它可能是____的菌落。
(4)从实验结果我们可以看出,手机上的细菌数目众多,而越来越多的人患上了“手机依赖症”,你对此有什么建议?____。

|培养基编号|培养基组成|
|甲|牛肉汁、蔗糖、水等|
|乙|牛肉汁、琼脂、水等|
(1)如图,在固定面积用无菌棉签取样,制成细菌悬液,然后取该悬液在培养基上涂抹,这个步骤即为接种,该步骤前需要对培养基进行____。
(2)该实验需选用培养基____(填“甲”或“乙”),原因是____可以使培养基凝固,以便观察实验结果。
(3)培养基上生长的菌落有多种形态,如果菌落较大且呈绒毛状,它可能是____的菌落。
(4)从实验结果我们可以看出,手机上的细菌数目众多,而越来越多的人患上了“手机依赖症”,你对此有什么建议?____。
答案:
(1)高温灭菌后冷却
(2)乙 琼脂
(3)真菌
(4)合理控制手机使用时间,多参加户外活动(合理即可)
(1)高温灭菌后冷却
(2)乙 琼脂
(3)真菌
(4)合理控制手机使用时间,多参加户外活动(合理即可)
查看更多完整答案,请扫码查看


